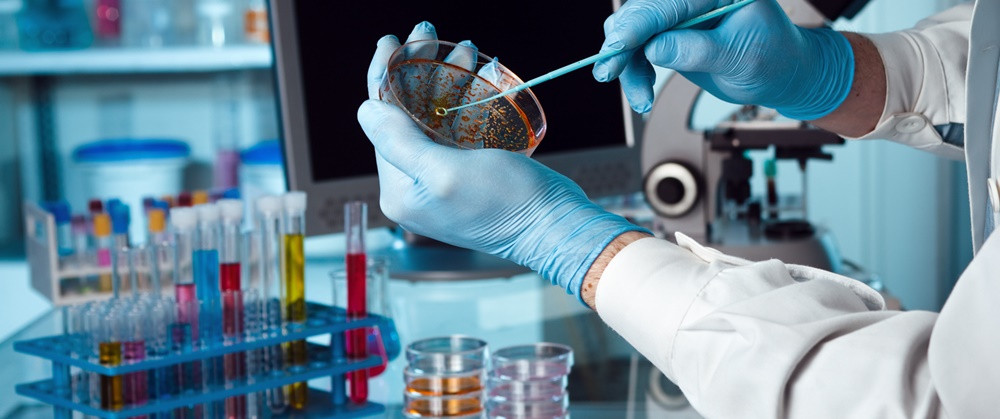

- Enseignant: Amina DERRADJIA
Ce TD est destiné aux étudiants de Master en Biochimie Appliquée et vise à développer leur compréhension des mécanismes d’action des médicaments à travers une approche basée sur l’analyse critique d’articles scientifiques.
Dans le cadre de ces séances, les étudiants seront amenés à réaliser des exposés individuels ou en groupe portant sur des publications scientifiques récentes en pharmacologie expérimentale. Pour chaque séance, un thème spécifique sera proposé, et les étudiants devront effectuer une recherche bibliographique afin de sélectionner un article scientifique pertinent en lien avec ce thème.
Chaque étudiant devra analyser l’article choisi en profondeur et présenter :
· Le contexte scientifique et les objectifs de l’étude
· Le modèle expérimental utilisé (in vitro, in vivo, essais précliniques, etc.)
· Les méthodes analytiques et biologiques employées
· Les résultats obtenus et leur interprétation
· Le mécanisme pharmacologique du ou des composés étudiés
- Enseignant: Djamila YSSAAD

L’hématologie est la spécialité médicale s’intéressant aux éléments constituant le sang (globules rouges et blancs, plaquettes sanguines…), la lymphe et les organes les sécrétant (moelle osseuse, rate, amygdales) ainsi qu’aux maladies qui y sont liées.
- Enseignant: NORA BENAICHETA

La biochimie et la physiologie étudient le vivant en combinant l'analyse des structures des organes et de leur mécanisme fonctionnel. L'objectif de ce cours est d'expliquer l'anatomie et le fonctionnement physiologique du système nerveux, qu'il soit central, périphérique ou anatomique, et d'aborder son intervention dans le maintien de l'homéostasie du milieu intérieur. Le contenu du cours porte sur toutes les notions concernant le milieu intérieur dans lequel vivent les cellules de l'organisme humain, puis aborde la physiologie de la régulation de la pression artérielle et les fonctions et les propriétés de différents organes, à savoir le cœur et le rein.
- Enseignant: Sadia BERZOU
Le cours de pharmacologie est destiné aux étudiants M1 Biochimie appliquée. Ce cours aborde les principes généraux de la pharmacologie, notamment la pharmacocinétique (absorption, distribution, métabolisme et élimination des médicaments) et la pharmacodynamie (mécanismes d’action, relation dose–effet, récepteurs). Une attention particulière est portée au rôle des enzymes, des voies métaboliques, et des biomolécules dans l’action et le devenir des substances pharmacologiques.
Les étudiants seront également initiés aux notions de toxicologie, d’effets indésirables, d’interactions médicamenteuses, ainsi qu’aux méthodes expérimentales utilisées en pharmacologie moderne. Des exemples appliqués en lien avec la biochimie (enzymes, récepteurs, signalisation cellulaire) permettront de relier la théorie à des situations pratiques et professionnelles.
- Enseignant: Djamila YSSAAD
Medical microbiology is an essential discipline that studies pathogenic microorganisms responsible for infections in humans and animals, as well as the methods used for their identification and therapeutic management. This course, intended for Master 1 students in Applied Biochemistry, aims to provide students with the knowledge and skills necessary to understand the role of microorganisms in human health, infectious diseases, as well as diagnostic and treatment methods.
- Enseignant: Zineb BELHAMRA